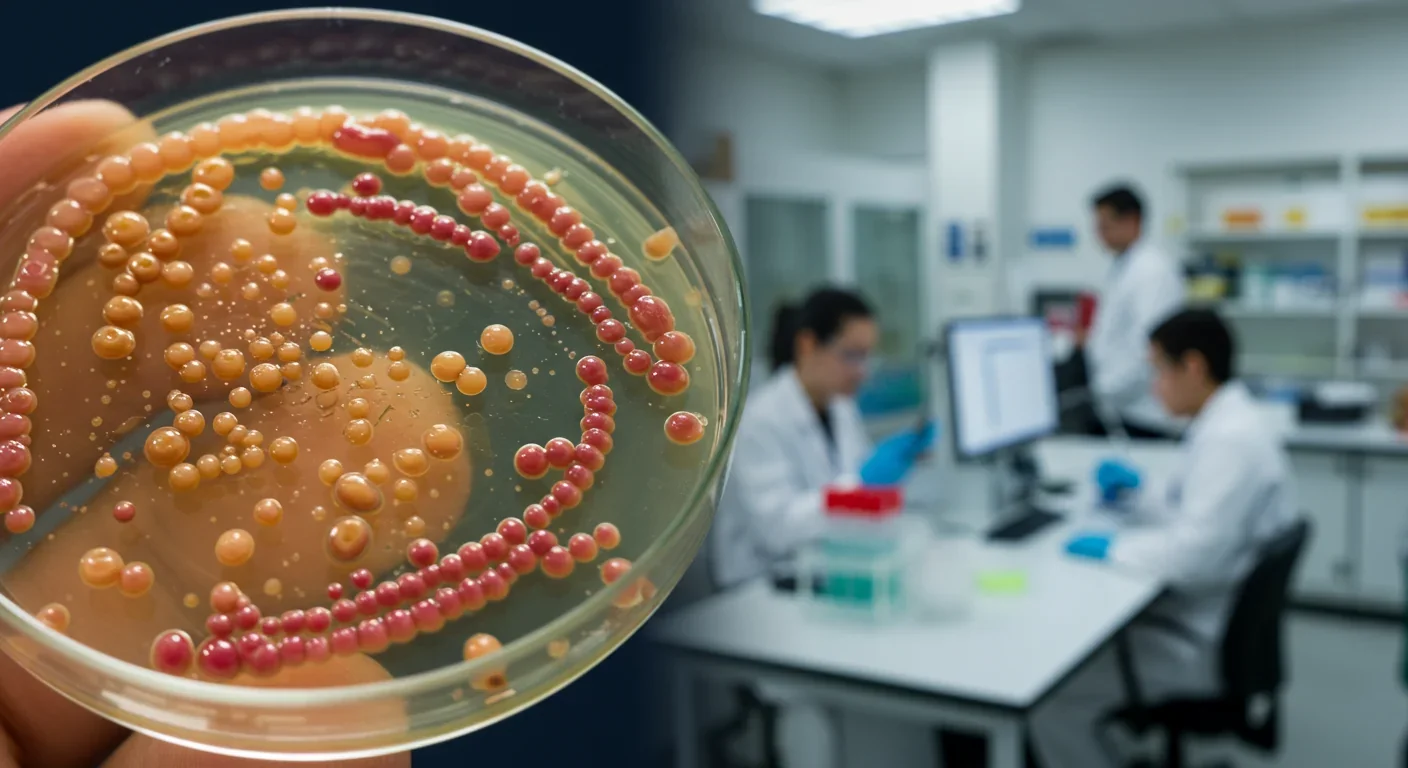

Keystone Bacteria: The Missing Link in Your Gut Health
TL;DR: Multiomics integration combines genome, proteome, and metabolome analysis to predict diseases years before symptoms appear, revolutionizing preventive medicine with unprecedented accuracy for conditions like cancer and Alzheimer's.
Within the next decade, you'll likely walk into a clinic, provide a few samples, and leave with a detailed forecast of diseases you might face in ten, twenty, or thirty years. Not guesses based on family history or single genetic markers, but predictions drawn from reading three distinct molecular languages your body speaks simultaneously: your genome, proteome, and metabolome.
This isn't science fiction. It's multiomics integration, and it's quietly transforming how we think about disease prediction from reactive medicine to proactive prevention.
Traditional genetic testing reads one chapter of your biological story. You send off a saliva sample, get results about specific gene variants, and learn you carry a BRCA mutation that increases breast cancer risk. Useful, sure, but incomplete. Your genes are instructions written at birth, but they don't capture what's happening right now in your body.
Enter multiomics: the simultaneous analysis of your genome (DNA instructions), proteome (proteins your cells are actually making), and metabolome (small molecules produced by cellular processes). Think of it as the difference between reading a recipe, watching a chef cook, and tasting the finished dish. Each layer reveals something the others miss.
Recent research published in Genome Medicine demonstrates how integrating metabolomics and proteomics identifies novel drug targets for heart failure and atrial fibrillation that single-layer analysis would never catch. The integration doesn't just add information, it multiplies insights exponentially.
The numbers tell the story. Studies on Alzheimer's disease prediction show that combining multiple omics layers dramatically outperforms single-omic approaches, catching warning signs years before cognitive symptoms appear. We're talking about prediction windows that stretch from months to potentially decades.
Medicine has always played catch-up. You feel symptoms, visit a doctor, get diagnosed, start treatment. By that point, cancer has been growing for years, neurons have been dying silently, arteries have been quietly clogging. Traditional diagnostics arrive fashionably late to the party.
Genomics promised to change that. When the Human Genome Project wrapped up in 2003, breathless headlines predicted personalized medicine based on DNA alone. Two decades later, we've learned genes tell an important but insufficient story. Having a gene variant doesn't mean it's active. Being "at risk" doesn't capture current cellular reality.
The proteome adds that reality check. Proteins do the actual work in your cells, and measuring which proteins are abundant right now reveals biological processes in motion. Combined with metabolomics (tracking the chemical fingerprints left by those processes), you get a real-time snapshot of what your body is doing, not just what it might do.
Historical parallels help here. The microscope didn't just magnify what we already saw, it revealed an entire invisible world. The X-ray didn't improve physical examination, it showed us structures hidden beneath skin. Multiomics integration similarly unveils biological activity happening beneath the threshold of symptoms or traditional tests.
Let's demystify this. Multiomics integration starts with sample collection: blood, urine, tissue biopsies, or even breath. From these samples, different analytical platforms extract different molecular layers.
DNA sequencing reads your genome, identifying variants and mutations. Mass spectrometry measures thousands of proteins simultaneously, capturing which genes are actively being expressed. Nuclear magnetic resonance or additional mass spec identifies hundreds of metabolites, the chemical byproducts of cellular metabolism.
The real breakthrough comes from computational integration. Each omics layer generates massive datasets, but connecting them requires sophisticated algorithms and machine learning. Advanced multi-omics analysis platforms use AI to find patterns invisible to human researchers: correlations between gene variants, protein abundance, and metabolite signatures that collectively predict disease risk.
Think of it like weather forecasting. Meteorologists don't just measure temperature or barometric pressure or wind speed. They integrate all three (and dozens more variables) into computational models that predict storms days in advance. Multiomics does the same for your biological weather systems.
The technology has matured rapidly. What once required weeks in specialized labs can now be accomplished in days. Next-generation liquid biopsies like Galleri and CancerSEEK use multiomics principles to detect over 50 cancer types from a single blood draw, often before any symptoms appear.
The clinical applications are moving from labs to actual patient care. Cancer detection represents the most advanced frontier. Longitudinal multi-omics studies track how tumors evolve over time, identifying molecular signatures that predict which tumors will metastasize and which will respond to specific treatments.
For cardiovascular disease, machine learning applied to multi-omics data identifies patients at high risk for heart failure or atrial fibrillation years before clinical symptoms emerge. This isn't theoretical: physicians are already using these predictions to start preventive interventions earlier, dramatically improving outcomes.
Alzheimer's research shows even more promise. Integrative multi-omics approaches have identified molecular pathways active in preclinical Alzheimer's, creating risk scores that outperform traditional assessments. Imagine knowing at age 50 that you're on a trajectory toward cognitive decline at 70, giving you two decades to modify lifestyle factors, start preventive medications, or enroll in clinical trials.
Diabetes prediction has similarly evolved. Analysis of genetic and environmental interplay in metabolic profiles shows how diet, exercise, stress, and genetics interact over time to either promote or prevent metabolic disease. This enables truly personalized prevention strategies rather than one-size-fits-all advice.
Here's where optimism meets reality. A single multiomics analysis can generate terabytes of data per person. Storing, analyzing, and interpreting that information requires computational infrastructure most hospitals don't possess. Cloud computing helps, but raises thorny questions about data privacy and ownership.
Who owns your molecular data? If your proteome predicts future cancer, can insurers access that information? Should they? Current regulations like HIPAA weren't designed for predictive multiomics data that might reveal risks decades in advance. The legal framework is sprinting to catch up with the technology.
Cost remains a barrier, though it's falling fast. Early multiomics analyses cost tens of thousands of dollars. Today, multi-cancer early detection tests are approaching $1,000 per test, with the market projected to reach $7.52 billion by 2033 as prices continue dropping. Still, that's beyond reach for many, creating a troubling dynamic where the wealthy get decades of warning while others remain in the dark.
The equity implications are profound. If multiomics-guided prevention becomes standard care for those who can afford it, health disparities could widen dramatically. A two-tiered system where some people predict and prevent disease while others still rely on late-stage diagnosis would exacerbate existing inequalities.
Access issues extend beyond cost. The computational literacy required to interpret results creates another barrier. Getting a report that lists dozens of protein biomarkers and metabolite ratios means nothing without expert interpretation. Building the clinical workforce to translate multiomics data into actionable advice represents a massive training challenge.
There's a darker consideration rarely discussed in breathless tech coverage: the psychological burden of prediction. Learning you have elevated risk for Alzheimer's three decades before potential symptoms creates a kind of existential weight. Some people will use that information productively, others will spiral into anxiety.
The ethics get murkier with uncertain predictions. Multiomics doesn't offer certainties, it calculates probabilities. Being told you have 60% increased risk for a disease doesn't tell you whether you'll actually get it. How do people make life decisions, relationship choices, or financial plans around probabilistic forecasts?
False positives carry real costs. Aggressive screening or preventive treatments triggered by multiomics predictions could subject healthy people to unnecessary procedures, medications with side effects, and psychological stress. The multi-omics market is expanding rapidly, but validation of prediction accuracy requires long-term studies we're still conducting.
Different cultures view predictive medicine through different philosophical lenses. In the United States, there's characteristic faith that more information equals better outcomes, that knowledge empowers control over destiny. The American embrace of consumer genomics companies like 23andMe reflects a cultural appetite for personal data.
European approaches emphasize collective benefit and ethical guardrails. The EU's strict data protection regulations shape how multiomics data can be collected and used, prioritizing privacy over rapid innovation. Research focuses on population health benefits rather than individual prediction.
Asian nations, particularly China and South Korea, are investing heavily in multiomics infrastructure with different priorities. Multi-omics research trends show massive government-funded biobanks collecting data from millions of citizens, accelerating discovery but raising Western concerns about consent and surveillance.
Japan's approach reflects cultural attitudes about aging and health. With the world's oldest population, Japanese researchers are pioneering multiomics applications for healthy aging, focusing less on extending lifespan than on compressing morbidity into the final years of life.
This global variation in approach actually benefits the field. Different regulatory environments, ethical frameworks, and research priorities create a diverse ecosystem of innovation. Discoveries made in one context cross-pollinate to others, accelerating progress.
So what does this mean for you, right now, in 2025? First, understand that comprehensive multiomics analysis isn't yet standard care, but it's moving from research to clinical application faster than most realize. If you have strong family history of specific cancers or cardiovascular disease, ask your physician about multi-cancer early detection tests that use multiomics principles.
Second, participate in research if you have opportunity. Biobanks and longitudinal health studies need diverse participants to develop accurate predictive models. The UK Biobank, All of Us Research Program, and similar initiatives are building the datasets that will power tomorrow's personalized medicine.
Third, advocate for equitable access. The promise of multiomics integration only transforms healthcare if it reaches everyone, not just the wealthy. That requires policy changes, insurance coverage decisions, and investment in public health infrastructure.
Fourth, engage with the ethical questions now, before the technology makes them urgent. Have conversations about genetic privacy, predictive testing, and what you'd want to know about your future health. These personal boundaries matter.
The multiomics revolution is following a familiar technology curve: initially expensive and limited to specialized applications, then gradually cheaper and more widespread, eventually becoming so ubiquitous we forget it's revolutionary.
Within ten years, expect multiomics-based risk scores to be routine parts of annual checkups for many people. Within twenty, today's medicine will seem as primitive as pre-antibiotic healthcare looks to us now. The idea that we once treated everyone with the same disease identically, ignoring their unique molecular signatures, will seem absurd.
But technology alone doesn't determine outcomes. How we deploy multiomics integration, who gets access, what safeguards we implement, and how we handle the psychological and ethical challenges will shape whether this becomes a tool for universal health improvement or another driver of inequality.
The convergence of genome, proteome, and metabolome analysis represents genuine transformation in our ability to see disease coming and potentially stop it before it starts. That's extraordinary. Whether it becomes a source of widespread benefit or concentrated advantage depends entirely on choices we make right now about access, equity, and values.
Your body is already speaking three molecular languages simultaneously. We've finally learned to listen to all of them at once. What we do with that conversation will define the next chapter of medicine.
Fast Radio Bursts—millisecond flashes from distant galaxies releasing more energy than the Sun in days—have evolved from cosmic oddities into powerful tools. Advanced telescopes like CHIME now detect dozens weekly, tracing origins to specific galaxies and even individual stars. Magnetars, ultra-magnetized neutron stars, are confirmed sources, yet mysteries abound: repeaters in dead galaxies, second-scale periodicities, and absence of X-ray counterparts. FRBs now map invisible baryons, measure...
Scientists are revolutionizing gut health by identifying 'keystone' bacteria—crucial microbes that hold entire microbial ecosystems together. By engineering and reintroducing these missing bacterial linchpins, researchers can transform dysfunctional microbiomes into healthy ones, opening new treatments for diseases from IBS to depression.
Marine permaculture—cultivating kelp forests using wave-powered pumps and floating platforms—could sequester carbon 20 times faster than terrestrial forests while creating millions of jobs, feeding coastal communities, and restoring ocean ecosystems. Despite kelp's $500 billion in annual ecosystem services, fewer than 2% of global kelp forests have high-level protection, and over half have vanished in 50 years. Real-world projects in Japan, Chile, the U.S., and Europe demonstrate economic via...
Our attraction to impractical partners stems from evolutionary signals, attachment patterns formed in childhood, and modern status pressures. Understanding these forces helps us make conscious choices aligned with long-term happiness rather than hardwired instincts.
Crows and other corvids bring gifts to humans who feed them, revealing sophisticated social intelligence comparable to primates. This reciprocal exchange behavior demonstrates theory of mind, facial recognition, and long-term memory.
Cryptocurrency has become a revolutionary tool empowering dissidents in authoritarian states to bypass financial surveillance and asset freezes, while simultaneously enabling sanctioned regimes to evade international pressure through parallel financial systems.
Blockchain-based social networks like Bluesky, Mastodon, and Lens Protocol are growing rapidly, offering user data ownership and censorship resistance. While they won't immediately replace Facebook or Twitter, their 51% annual growth rate and new economic models could force Big Tech to fundamentally change how social media works.